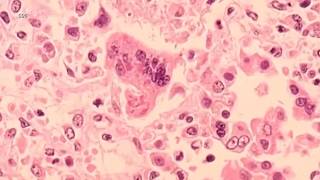

Hi! We're in New York City and hope you love us on YouTube as much as you do on television!
FAQs
Q: Where can I send a news tip?
A: You can email us using the link below or give us a call at 917-260-7700.
Q: How can I connect with Bill Ritter?
A: He's on Facebook and Twitter along with the rest of the Eyewitness News team.
Q: How do I send you a photo or video of a news event?
A: Use the hashtag #abc7NY or photos.abc7ny.com/ to upload.
Q: Where can I watch Eyewitness News Live?
A: Channel 7 on your TV, our website (abc7ny.com) or by downloading our Eyewitness News app or the ABC app.
Q: Where in New York City are you located?
A: On the beautiful Upper West Side of New York City at 67th and Columbus Avenue. We even have a streetside studio on the corner of 66th and Columbus so you can stand on the sidewalk and watch us, take selfies or dance.
Q: When did Eyewitness News debut?
A: In 1968 with Roger Grimsby.
Visit us at abc7ny.com/
Shared 5 hours ago
2K views
Shared 5 hours ago
1.6K views
Shared 5 hours ago
2.8K views
Shared 1 day ago
25K views
Shared 1 day ago
19K views
Shared 1 day ago
1.1K views
Shared 1 day ago
3.8K views
Shared 1 day ago
2.7K views
Shared 1 day ago
5.6K views
Shared 1 day ago
1K views
Shared 1 day ago
17K views
Shared 1 day ago
4.7K views
Shared 1 day ago
1.7K views
Shared 1 day ago
4.8K views
Shared 1 day ago
488 views
Shared 1 day ago
2.4K views
Shared 2 days ago
17K views
Shared 2 days ago
4.7K views
Shared 2 days ago
2.9K views
Shared 2 days ago
955 views
Shared 2 days ago
1.3K views
Shared 2 days ago
5.1K views
Shared 2 days ago
16K views
Shared 2 days ago
24K views
Shared 2 days ago
5.7K views
Shared 2 days ago
18K views
Shared 2 days ago
1.1K views
Shared 2 days ago
849 views
Shared 2 days ago
488 views
Shared 2 days ago
52K views
Shared 2 days ago
6.1K views
Shared 2 days ago
1.3K views
Shared 2 days ago
5.1K views
Shared 2 days ago
4.8K views
Shared 2 days ago
2.3K views
Shared 2 days ago
17K views
Shared 2 days ago
1.1K views
Shared 2 days ago
6.9K views
Shared 2 days ago
4.5K views
Shared 2 days ago
2.2K views
Shared 2 days ago
4.5K views
Shared 2 days ago
1.1K views
Shared 2 days ago
15K views
Shared 2 days ago
942 views
Shared 3 days ago
10K views
Shared 3 days ago
20K views
Shared 3 days ago
21K views
Shared 3 days ago
1.6K views
Shared 3 days ago
6.3K views
Shared 3 days ago
1.2K views